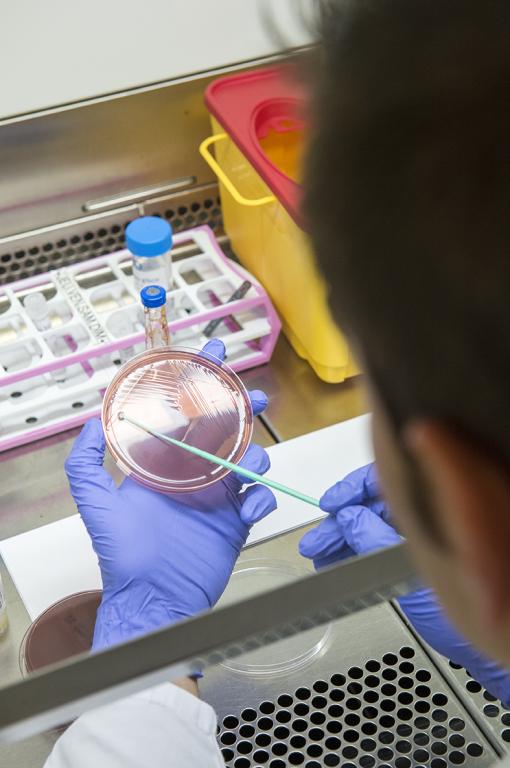

Bienvenue
La banque d’images illustre les formations et les professions présentées au CiPS.
Les photos sont accessibles et peuvent être utilisées selon les conditions mentionnées sur le site qu’il conviendra d’accepter.
Pour obtenir des images en haute définition, merci de nous adresser un e-mail à info@aoris.ch en mentionnant le contexte de leur utilisation.
Nous vous souhaitons une agréable recherche !
Santé
Social
Stages
Salon des métiers
Info-Métiers